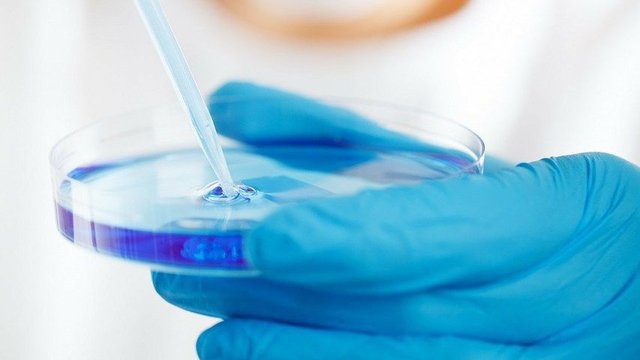
ГД_наука_био

Правительство утвердило план развития фармацевтической промышленности
14 апреля 2024 г. 9:00
Доля российских препаратов в общем объеме продаж на внутреннем рынке должна вырасти почти до 70% в ближайшие семь лет, об этом заявил премьер-министр Михаил Мишустин …